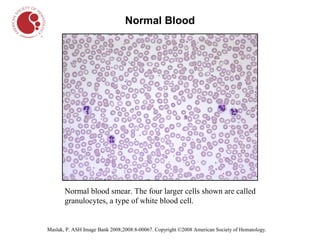
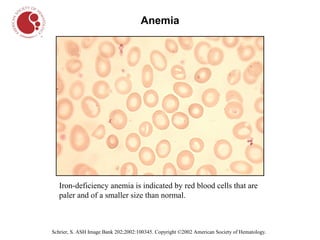
Anemia




   Iron-deficiency anemia is indicated by red blood cells that are
   paler and of a smaller size than normal.



Schrier, S. ASH Image Bank 202;2002:100345. Copyright ©2002 American Society of Hematology.

The document describes different types of blood cells and blood disorders through images from a blood smear. It shows normal red blood cells having a pale center, and normal white blood cells. Images then show the pale and smaller red blood cells of iron-deficiency anemia. Sickle cell anemia is indicated by sickled, crescent-shaped red blood cells. Chronic myelogenous leukemia shows increased white blood cells. Hairy cell leukemia features white blood cells with hair-like projections. Hodgkin lymphoma features large owl-like Reed-Sternberg cells.